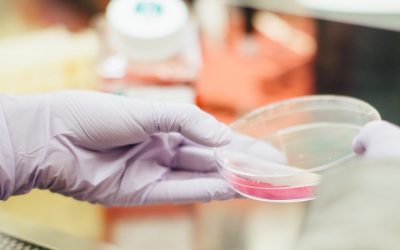
Frozen Embryo Replacement

If you’ve battled allergies all your life, then probably anti-histamines had become already a part of your routine. But what if you’re pregnant? Is it safe?
Blog News & Updates
Get the latest news and updates on our Infertility Workshop Blog: Mens Health Issues…
Choosing the Gender of Your Baby
Is it a boy or a girl? Some couples have gender preferences and some do not. But for those who would like to try influencing their baby gender, here are some methods we recommend.
The Basics You Need To Know About Natural & Organic Progesterone Cream And Fertility
Progesterone plays an essential role in fertility. Fertile Balance Organic Progesterone Cream contains USP-grade progesterone to help women curb symptoms of infertility and hormonal imbalance.
Frozen Embryo Replacement
Frozen embryo replacement is a process that involves the transfer of thawed embryo into the uterine cavity to increase the chances of pregnancy. But does it really help with infertility? Find the answers in this Infertility Workshop blog.
No Results Found
The page you requested could not be found. Try refining your search, or use the navigation above to locate the post.
Recent Post
Fertility Tracker
Finding the best fertility monitor device is one way to track ovulation effectively. Fertility Tracker is a powerful tool usefule in ovulation prediction through saliva testing. In this article, know why it’s the most recommended fertility tracker you can get.
Gender Prediction Test
Women who are pregnant usually can’t wait to determine their baby’s gender. One way to know is by using gender prediction test kits from reliable manufacturers. See the best prediction test kits and their features here.
Female Hormone Balance: Natural Herbs for Hormone Balance
If you are looking for a safe and natural way to balance your hormones, Female Hormone Balance is the perfect fit for you. Read more about this natural supplement here in the blog of Infertility Workshop.
Track Fertility Using Digital Basal Thermometer
Using a digital basal thermometer is the easiest and most economical method to track your fertility. Check this blog to completely grasp the significance of basal thermometer. Read now.
What Is the Best Way to Track Fertility?
Tracking fertility is a personal choice since some of the methods are tedious and costly. We uncover here the most reliable ways you can try in tracking fertility.